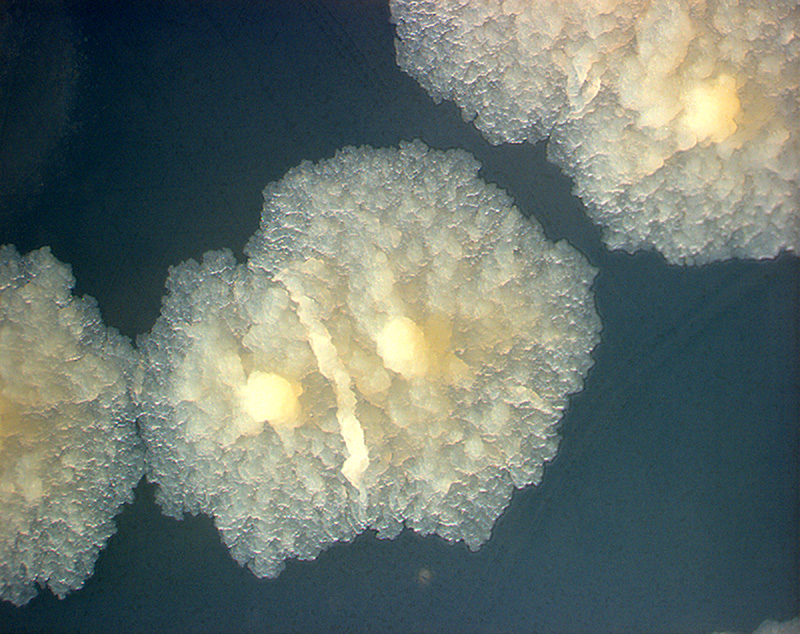

Edvard Munch
12 dec 1863, Løten – 23 jan 1944, Oslo, Noorwegen
Of Munch nu landschappen, portretten, mythologische onderwerpen of arbeiders terugkerend van hun werk schilderde of zijn kleuren nu donker of licht waren, zijn werk drukt altijd angst, dood en liefde uit.
♦ Het zieke kind (1885) ♦
♦ Diagnose:
Belangrijkste verschijnselen: Uitgeputte puber, bleek gelaat, starende blik
Nevenverschijnselen: Meisje van 15 jaar, hopeloze moeder, familiegeschiedenis van tuberculose
Klinische diagnose: Tering (ftisis), eindstadium (long-)tuberculose
♦ Definitie: ftisis
Oude term voor tuberculose, in het bijzonder voor longtuberculose, een ziekte gekenmerkt door uitputting en krachtverlies, in het bijzonder bij longziekten.
♦ Bespreking:
Edvard Munch werd in 1863 geboren in Christiana, dat toen nog bij Zweden hoorde, maar nu de Noorse hoofdstad Oslo is. Zijn vader was een legerarts, die in een arbeiderswijk in Oslo ook een privépraktijk hield. Godvrezend en vroom als hij was, voedde hij zijn 5 kinderen op met een puriteinse strengheid. Het huis van de dokter was een plek vol vroomheid, ziekte en dood.
Edvard was 5 jaar oud toen zijn moeder aan tuberculose stierf. Ook zijn lievelingszus Sophie stierf aan die ziekte toen ze pas 15 was. In die dagen stierven mensen niet in een ziekenhuis, maar thuis, omringd door de familie met alle problemen en ellende van dien. Laura, de andere zus van Edvard, was geestesziek en stierf in een inrichting. Toen ook zijn vader stierf, was de jonge Edvard nog lang niet oud genoeg om voor zichzelf te zorgen.
Munch trachtte aan die verstikkende atmosfeer te ontsnappen in zijn tekeningen en schilderijen. Met zijn kunst vocht hij ook tegen zijn eigen ziekten. Hij leed aan bronchitis, reumatiek en zenuwzwakte. Hij had een drankprobleem tot 1909 en was extreem paranoïde tot aan zijn dood. Hij voelde zich achtervolgd, in het bijzonder door vrienden en vrouwen. Als hij verliefd werd, was hij altijd paranoïde jaloers. Hij had het gevoel dat vrouwen hem benauwden en bedreigden en slechts op één ding uit waren: hem te beroven van zijn vrijheid.
Ondanks het feit dat hij diverse romances beleefde, trouwde hij nooit en had hij geen kinderen.
‘Mijn schilderijen zijn mijn enige kinderen’, zei hij ooit.
Hij begon zijn artistieke carrière met portretten van zichzelf, zijn familie en zijn vrienden.
Zijn latere zelfportretten hadden iets spookachtigs, terwijl vrouwen op zijn schilderijen er etherisch uitzien, lijkend op heksen of vampiers.
Een van zijn beroemdste schilderijen, Het zieke kind (1885), illustreert de dood van zijn zuster. Munch zelf beschouwde dit schilderij als het fundament van zijn kunst.
Het niet minder beroemde De schreeuw (1893) wordt beschouwd als een uitstekend voorbeeld van expressionistische kunst.
Zijn werk lokte veel kritiek uit, waardoor Munch uiteindelijk zijn land ontvluchtte. Hij reisde door Europa en organiseerde er tentoonstellingen.
Hij schilderde, filosofeerde en verzorgde zijn ziekten. Hij wist dat ze de bron van zijn artistieke inspiratie waren. De Duitse kinderarts Lothar Diekmeier maakte in zijn publicatie over beroemde afbeeldingen van zieke kinderen (1954) een meesterlijke beschrijving van Munchs ‘Het zieke kind’ die we hier integraal weergeven:
Hoogopgericht op haar ziekbed zit het 12 tot 14 jarig meisje, haar hoofd met het roodblonde haar scherp in profiel, de blik uit haar grote, door een halo omgeven ogen star en onverschillig op het venster gericht. Berustend en al bevrijd van al haar ongelukkige ervaringen ligt ze daar krachteloos. Slap rust haar bleke hand op de deken en onderstreept haar totale gelatenheid tegenover de noodlottige ziekte die onder haar leden woedt. De moeder weet zich geen houding meer te geven. Ze weent slechts stilletjes in zichzelf en controleert slechts met een reflexmatige aanraking of haar kind nog leeft. Alles aan haar straalt zoveel vertwijfeling uit dat de uitdrukking van haar houding en haar gebaren de toeschouwer sterker aangrijpen dan de aanblik van het haar haast ontrukte kind.
Hoe schril, wrang en zwaar die kleuren, hoe verbluffend die vereenvoudiging van de vormen.
Hoe echt en gespeend van elke sentimentaliteit de vormgeving van het hele werk.
Als het ware is dat elke tijdperk in de kunstgeschiedenis de ziekten van zijn eigen tijd heeft afgebeeld, kan men hier alleen maar aan ‘ftisis’ of nauwkeurige nog ‘puberteitsftisis’ denken.
Geschokt staat men voor deze 2 mensen en keert men zich uiteindelijk af, alsof ze echt van vlees en bloed waren. Niets immers kan dit meisje nog redden, niemand is in staat de moeder te troosten met het verlies van wellicht haar enige kind dat zich hier voor onze ogen voltrekt.
Bron: Jan Dequeker
♦ Longtuberculose
Is een infectieziekte die wordt veroorzaakt door de bacterie Mycobacterium tuberculosis.
Ieder deel van het lichaam kan worden aangedaan, maar meestal raken de longen geïnfecteerd.
Longtuberculose komt het meeste voor in dichtbevolkte landen als China en India en verder in Afrikaanse landen ten zuiden van de Sahara, Indonesië, de Filippijnen, Afghanistan, Bolivia en Peru. Het aantal gevallen van longtuberculose in Noord-Amerika en West-Europa liep een tijdlang terug, maar de laatste jaren is er weer een toename te zien. Dat wordt deels toegeschreven aan het feit dat er steeds meer mensen buitenlandse reizen maken, waardoor de infectie zich kan verspreiden naar gebieden waar tuberculose voorheen weinig meer voorkwam.
Een andere factor die ten grondslag ligt aan deze stijging is het groeiend aantal gevallen van aids.
♦ Oorzaak
Besmetting vindt voornamelijk plaats van mens op mens, via minuscule druppeltjes die in de lucht terechtkomen als een geïnfecteerde persoon niest, hoest of spuugt. Het grootste risico op besmetting lopen vrienden, familieleden en collega’s van een geïnfecteerde persoon.
Mensen met een verzwakt afweersysteem lopen ook een verhoogd risico, evenals jonge kinderen en ouderen. Bovendien komt de aandoening relatief veel voor onder mensen die in slechte sociaal-economische omstandigheden verkeren; andere risicofactoren zijn slechte woonomstandigheden, armoede, overbevolking, eenzijdige voeding, woningnood en gebrekkige gezondheidszorg.
Alcoholmisbruik en roken kunnen ook het risico op longtuberculose vergroten.
♦ Verschijnselen
Het voornaamste verschijnsel van longtuberculose is hoesten: in eerste instantie een droge hoest, maar gaandeweg wordt er meer slijm opgehoest, waar zich bloedsporen in kunnen bevinden. Bloed opgeven komt ook voor. In het begin kan de patiënt lichte koorts hebben, maar naarmate de ziekte voortschrijdt, wordt de koorts hoger, met name ‘s avonds. Er is verder sprake van aanzienlijk gewichtsverlies en de patiënt kan ’s nachts badend in het zweet wakker worden.
Andere symptomen die bij longtuberculose kunnen optreden, zijn kortademigheid, uitputting, algehele zwakte en een drukkend gevoel en/of pijn op de borst.
♦ Diagnose
De diagnose van longtuberculose wordt in eerste instantie gebaseerd op de klachten en een lichamelijk onderzoek. Er vindt een huidtest, de zogeheten Mantoux-test plaats, waarbij een gezuiverd eiwitderivaat (tuberculine) in de huid wordt gespoten. Deze test maakt echter geen onderscheid tussen een actieve infectie (die met symptomen gepaard gaat) en een latente infectie (die geen klachten veroorzaakt).
Thoraxfoto’s zijn van groot belang voor de diagnose van longtuberculose.
De diagnose kan worden bevestigd wanneer de bacterie wordt geïdentificeerd tijdens microscopisch onderzoek van het sputum of in een kweek van speeksel of sputum.
♦ Behandeling
De behandeling van longtuberculose is gebaseerd op een combinatie van twee of drie middelen om te voorkomen dat de bacterie resistent wordt tegen de medicijnen en om tegelijk de werkzaamheid ervan te vergroten. De duur van de behandeling varieert van zes tot twaalf maanden, afhankelijk van hoe de patiënt erop reageert.
♦ Complicaties
Longtuberculose kan de longen blijvend beschadigen. De medicijnen die worden gebruikt bij de behandeling ervan, kunnen leiden tot bijwerkingen. Ook kan de bacterie op den duur resistent worden tegen de betreffende middelen, vooral wanneer die niet volgens voorschrift worden ingenomen of als er te vroeg mee wordt gestopt. Tuberculose kan behalve de longen bijna elk orgaan in het lichaam aantasten.
♦ Preventie
Het verbeteren van sociale factoren en leefomstandigheden helpt tuberculose te voorkomen. Specifieke preventie kan worden bereikt door inenting met BCG: dit vaccin is vooral effectief bij baby’s en kinderen.
Vroege opsporing en behandeling van geïnfecteerde personen helpt te voorkomen dat de infectie zich verspreidt. Geïnfecteerde mensen dienen zolang zij besmettelijk zijn, te worden geïsoleerd in speciaal geventileerde ruimten.